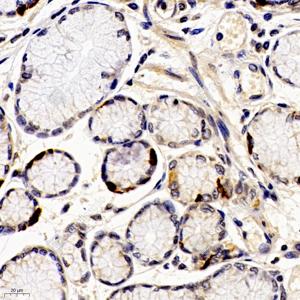

Anti-ANKK1 Rabbit pAb
- 50 μL
产品信息
|
蛋白质全称 |
含锚蛋白重复和激酶结构域的蛋白1 |
|
别名 |
Ankk1, X kinase, Sugen kinase 288, SGK288, Protein kinase PKK2, PKK2 |
|
Uniprot ID |
Q8BZ25 |
|
免疫原 |
KLH偶联的小鼠ANKK1合成肽 |
|
抗体亚型 |
IgG |
|
纯化方式 |
亲和纯化 |
|
亚细胞定位 |
细胞核 |
应用
| 应用 | 物种 | 稀释 | 阳性样品 |
| IHC/IF 免疫组织化学/免疫荧光 | 人 | 1: 100-1: 400 | 结肠, 胃癌 |
背景
ANKK1 (ankyrin repeat and kinase domain containing 1), also known as PKK2 or SGK288, is a 765 amino acid protein that belongs to the Ser/Thr protein kinase family and contains 12 ANK repeats and one protein kinase domain. Highly expressed in brain tissue and present in lower amounts in placenta and spinal cord, ANKK1 functions to catalyze the ATP-dependent phosphorylation of target proteins and is thought to play a role in alcohol and nicotine dependence. The gene encoding ANKK1 maps to human chromosome 11, which houses over 1,400 genes and comprises nearly 4% of the human genome.
图像
|
|
IHC检测ANKK1蛋白(货号 GB112377). 样品: 人结肠, 4%多聚甲醛 (货号G1101) 固定12-24小时. 抗原修复: 柠檬酸抗原修复液(干粉, pH 6.0) (G1201), 98℃, 20分钟. —抗: 1: 200稀释, 4℃ 孵育过夜. 二抗: HRP标记山羊抗兔IgG (H+L) (货号GB23303), 1: 200稀释, 室温孵育1小时. |
|
|
IHC检测ANKK1蛋白(货号 GB112377). 样品: 人胃癌, 4%多聚甲醛 (货号G1101) 固定12-24小时. 抗原修复: 柠檬酸抗原修复液(干粉, pH 6.0) (G1201), 98℃, 20分钟. —抗: 1: 200稀释, 4℃ 孵育过夜. 二抗: HRP标记山羊抗兔IgG (H+L) (货号GB23303), 1: 200稀释, 室温孵育1小时. |
储存
| 储存条件 | 在-20℃下储存一年, 避免反复冻融. |
| 储存缓冲液 | 含0.15% ProClin300防腐剂, 100 μg/mL牛血清白蛋白和50%甘油的磷酸盐缓冲液. |
注意:
1.本产品仅供研究使用.
2.建议用一抗稀释液(G2025)稀释本产品.
| 货号 | 名称 | 规格 | 价格 | 操作 |
|---|
| 货号 | 名称 | 规格 | 价格 | 操作 |
|---|